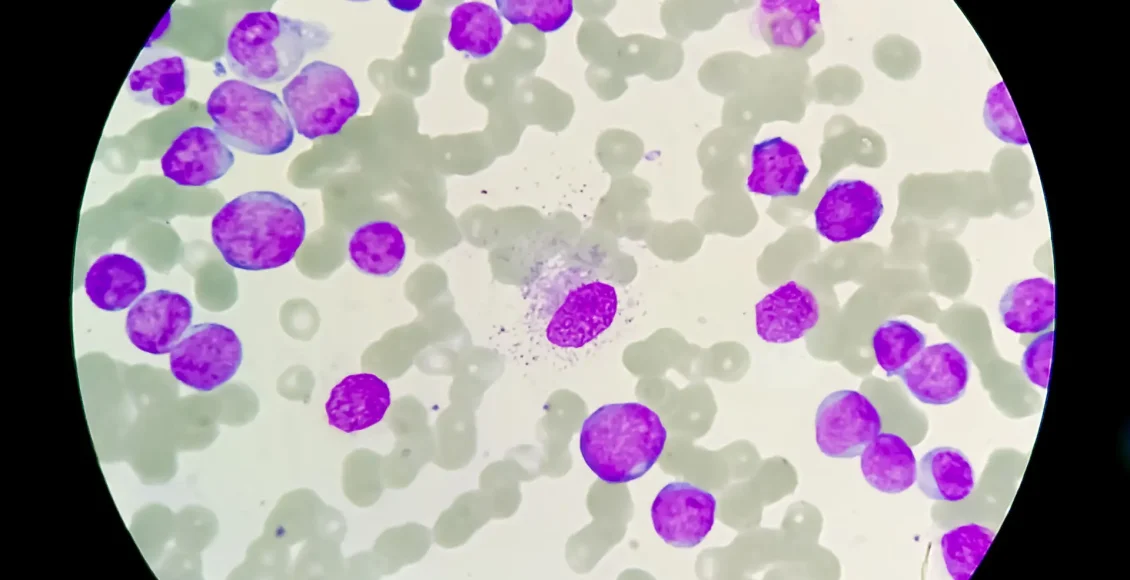

Une étude clinique récente publiée dans la revue de référence The Lancet Haematology ouvre une nouvelle perspective dans la prise en charge des leucémies aiguës myéloïdes en rechute ou résistantes. Face à une maladie réputée particulièrement difficile à traiter dans ces situations, les chercheurs proposent une stratégie combinant thérapies ciblées et chimiothérapie intensive, avec des résultats jugés prometteurs.
L’essai, baptisé RELAX, s’est intéressé à des patients atteints de leucémie aiguë myéloïde ayant échoué aux traitements standards. Dans ce contexte, les options thérapeutiques sont limitées et le pronostic reste souvent sombre. L’étude explore l’association du vénétoclax — une molécule ciblant les mécanismes de survie des cellules cancéreuses — avec une chimiothérapie à base de cytarabine à forte dose et de mitoxantrone.
Les résultats montrent que cette combinaison permet d’obtenir des taux de réponse significatifs, y compris chez des patients lourdement prétraités. En d’autres termes, une proportion non négligeable de malades voit leur maladie régresser, ce qui constitue un enjeu majeur dans cette phase avancée de la pathologie. Cette réponse thérapeutique ouvre notamment la voie à une greffe de cellules souches, souvent considérée comme la seule option potentiellement curative dans ces situations.
Au-delà des chiffres, l’étude met en lumière un changement de paradigme dans le traitement des cancers hématologiques. L’intégration des thérapies ciblées comme le vénétoclax dans des protocoles intensifs semble renforcer l’efficacité globale, en s’attaquant simultanément à plusieurs mécanismes de résistance tumorale. Cette approche combinée pourrait ainsi devenir un standard dans les années à venir, sous réserve de confirmation par des essais plus larges.
Les chercheurs soulignent toutefois que cette stratégie n’est pas dénuée d’effets secondaires. La toxicité hématologique reste importante, nécessitant une surveillance étroite et une prise en charge spécialisée. Mais dans un contexte où les alternatives sont rares, le rapport bénéfice-risque apparaît favorable.
Cette avancée s’inscrit dans une dynamique plus large d’innovation en hématologie, où les traitements deviennent de plus en plus personnalisés et ciblés. Elle confirme également le rôle central des essais cliniques dans l’amélioration des chances de survie des patients atteints de cancers du sang.
En filigrane, une réalité persiste : la lutte contre les leucémies agressives reste un défi majeur. Mais avec ce type de stratégie thérapeutique, la médecine semble peu à peu reprendre l’initiative face à des formes de cancer longtemps considérées comme presque inaccessibles.
Ouiza Lataman